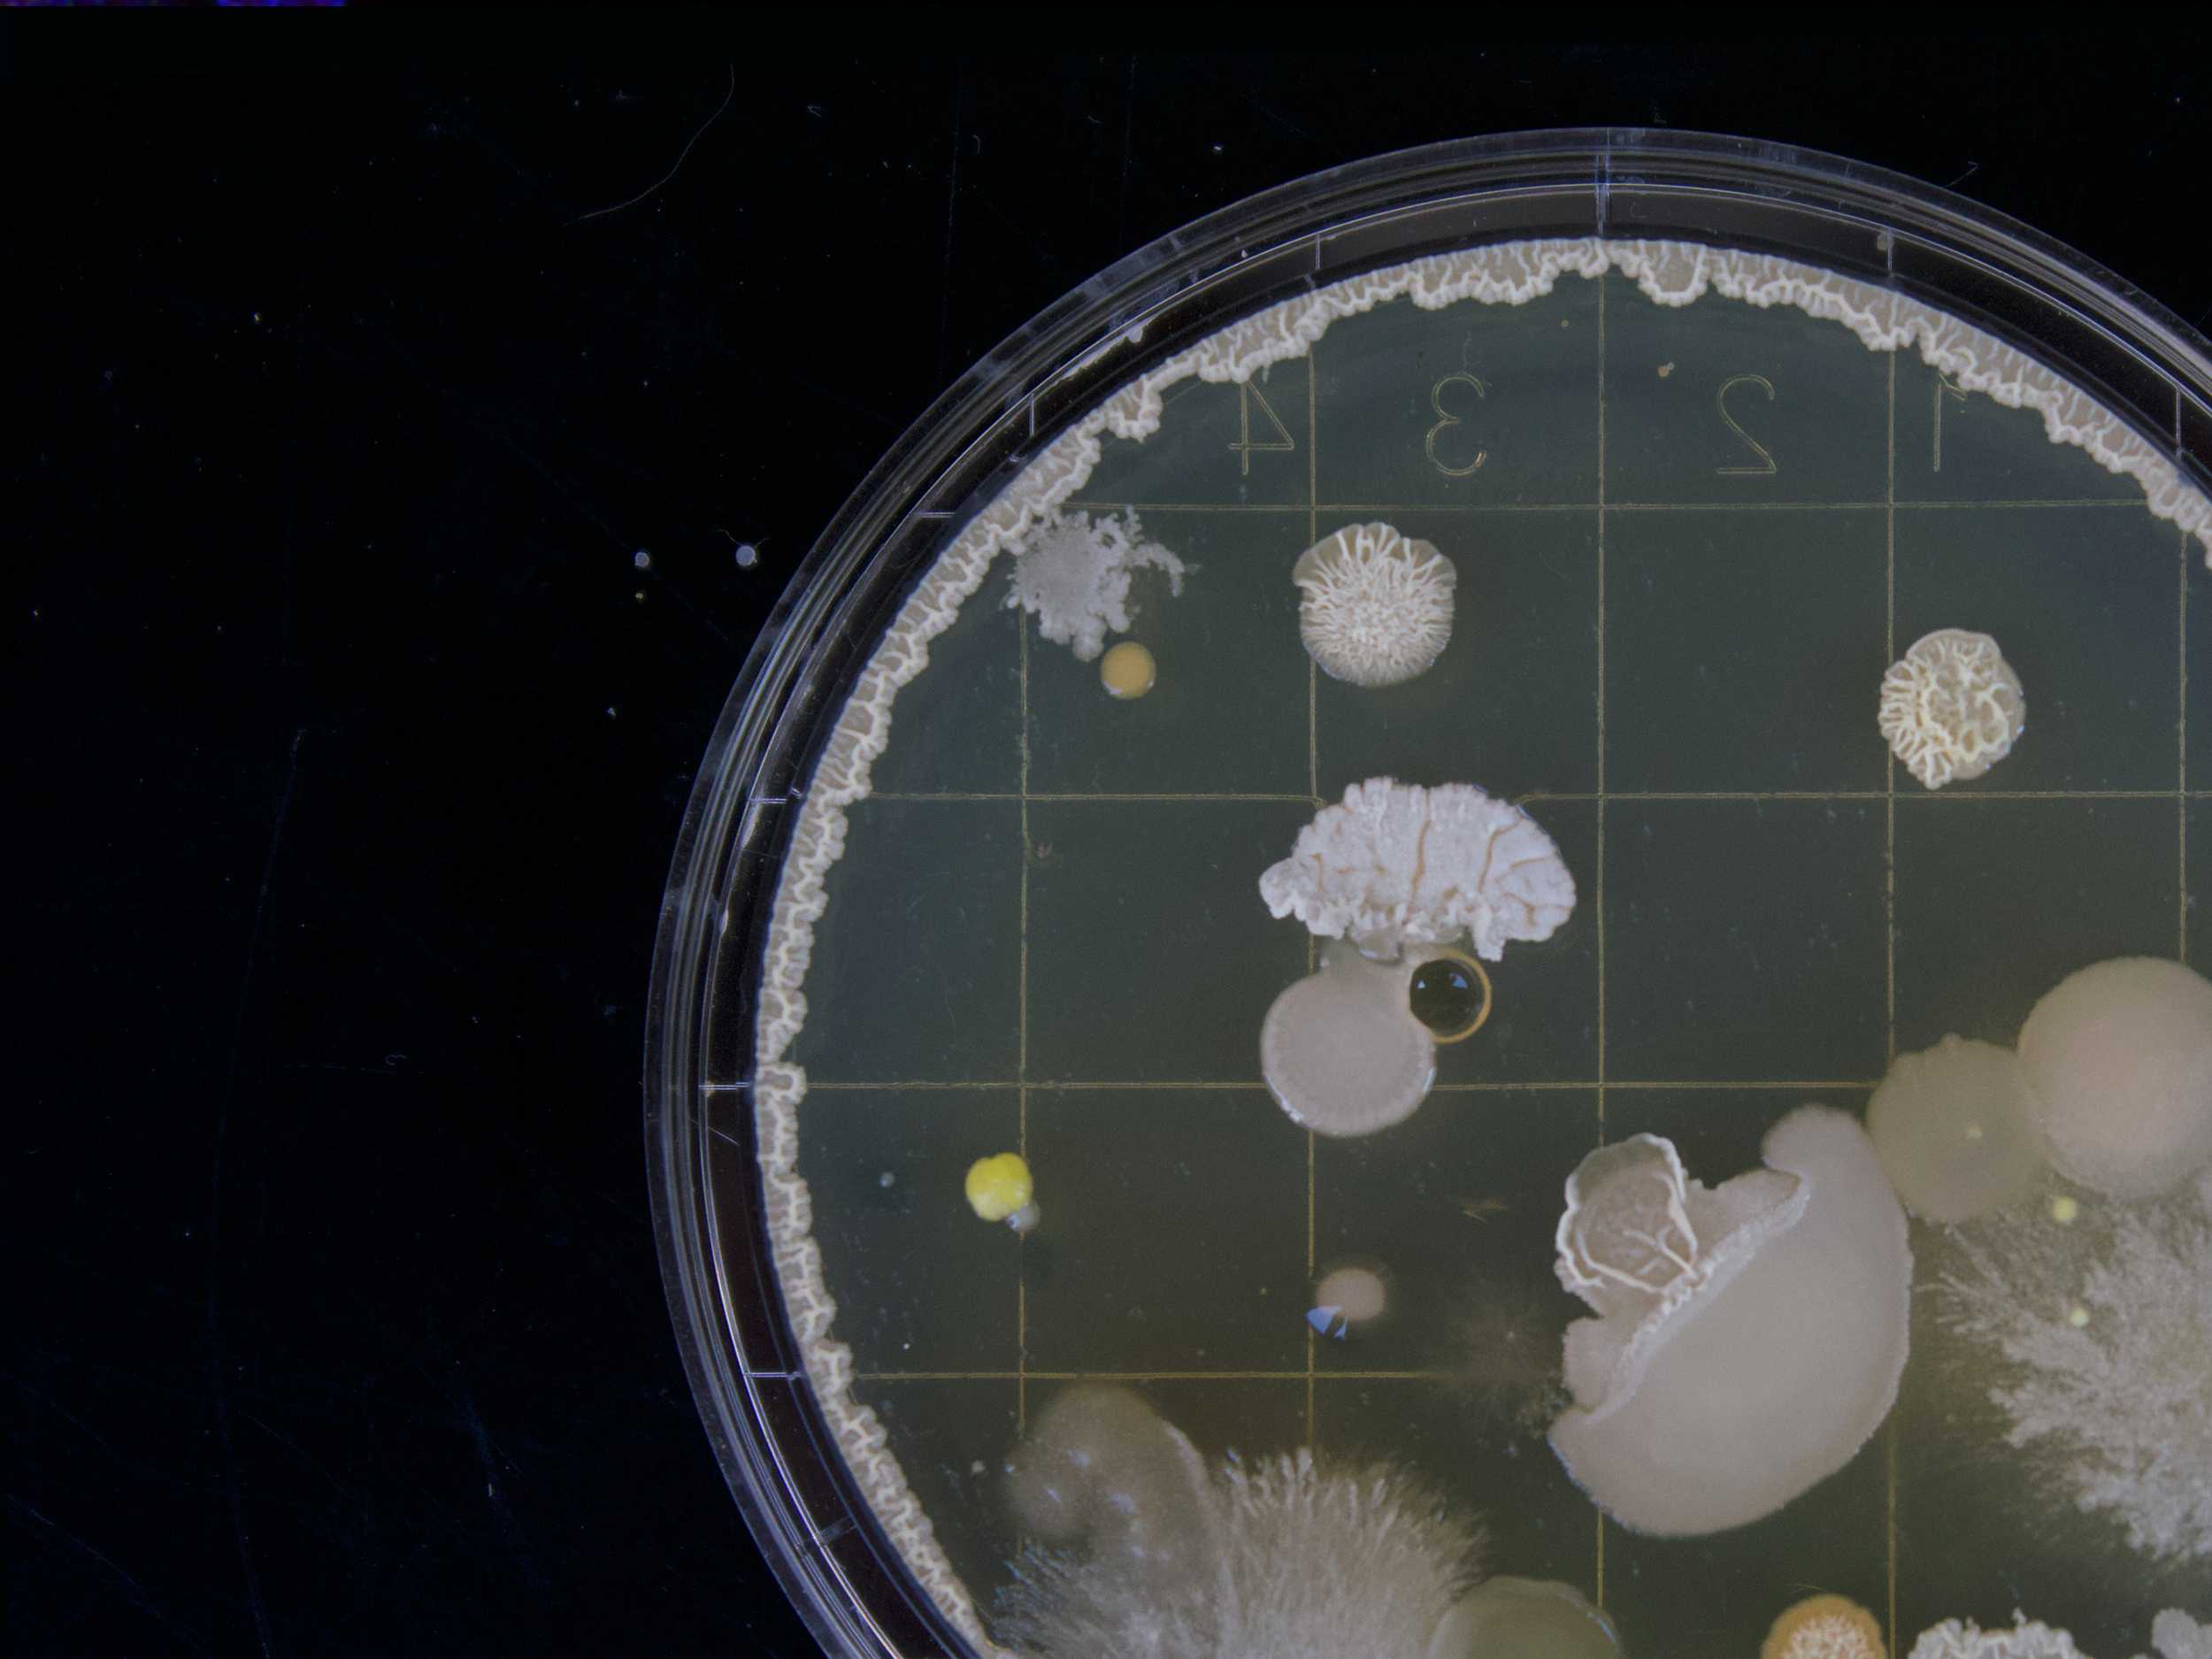
Bacteria sample
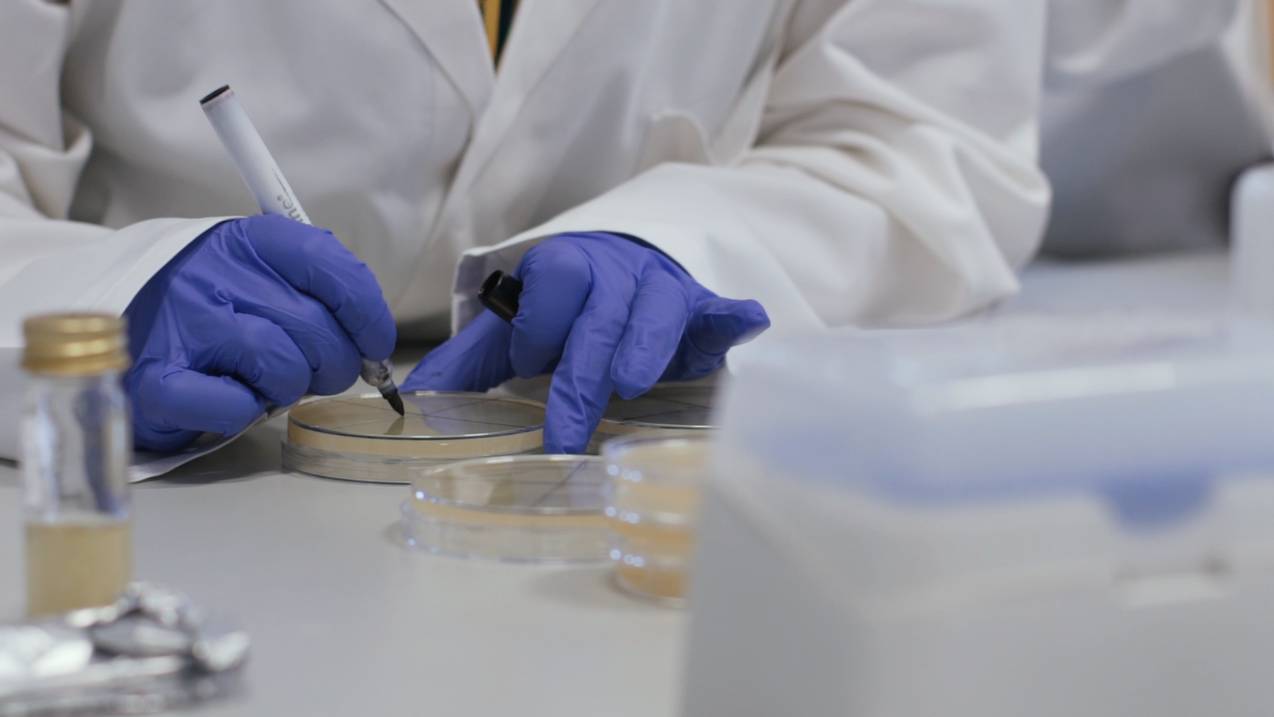
Close-up of student writing on petri dishes

STUDY
| Institution code: | S82 |
|---|---|
| UCAS code: | J750 |
| Start date: | September 2025 |
| Duration: | Three years full-time, six years part-time |
| Location: | Ipswich |
| Typical Offer: | 112 UCAS tariff points (or above), BBC (A-Level), DMM (BTEC) |
| Institution code: | S82 |
|---|---|
| UCAS code: | J750 |
| Start date: | September 2025 |
| Duration: | Three years full-time, six years part-time |
|---|---|
| Location: | Ipswich |
| Typical Offer: | 112 UCAS tariff points (or above), BBC (A-Level), DMM (BTEC) |
Overview
Biomedical science is a dynamic and rapidly evolving scientific discipline aimed at improving our understanding of human health and disease.
The course has a strong practical focus and it will provide you with a wide range of practical and analytical skills relevant to a career in biomedical science and wider. Our aim is to help you progress to an employment-ready graduate and hence the course is designed to also equip you with a number of transferable skills that are so highly valued in the current, ever-changing, employment market.
This course utilises a multidisciplinary approach in order to provide you with knowledge of workings of human body at molecular, cellular, organ and systems level, in health and disease. It covers the key aspects and principles of biochemistry, molecular biology, immunology, physiology and pathophysiology, histology and haematology.
The course benefits from a close working relationship with Ipswich Hospital and is taught by an international team of research-active academics. Both of these ensure that the course is relevant to your future employment, is contemporary and at the forefront of science.
Further information about the university's relationship with the Institute of Biomedical Science (IBMS) is available in the PSRB register.
.jpg)
Accredited by the Institute of Biomedical Science (IBMS), the leading professional body for scientists, support staff and students in the field of biomedical science. It can be used towards obtaining statutory registration as a biomedical scientist with the Health and Care Profession Council (HCPC) through completion of the IBMS Registration Training Portfolio and award of the IBMS Certificate of Competence.
Biomedical Science at the University of Suffolk

Course Modules

DNA is arguably the most important macromolecule in life and this module is designed to provide a solid foundation of knowledge on which students can build throughout the Bioscience degree programme. Beginning with the fundamental concepts of DNA and it’s role in heredity and the genetic code, the module will build up through expression of genotype to phenotype and the control of gene expression.
A thorough understanding of human physiology and maintenance of homeostasis are key facets in a range of scientific disciplines. In this module, students will study the way in which different cells, tissues, organs and organ systems contribute to homeostasis from a theoretical perspective.
This module is designed to give a solid foundation on which to build further study in biological science. It will investigate the fundamentals of biochemistry starting from basic atomic structure and bonding to then focus on the structure, function and metabolism of macromolecules. Students with differing levels of previous knowledge of chemistry and biology will be introduced to the range of processes taking place within the body at a molecular level.
Cells are the basic unit of all living organisms. In this module, students will examine the structure and function of cells, and the signals that control eukaryotic cell division, adhesion, migration, and programmed cell death. Students will analyse how cells contribute to animal physiology and disease, and be introduced to the techniques used to study cells in the laboratory.
This module will provide you with the core skills required to carry out basic scientific procedures and communicate your research in an appropriate scientific format. The module is based on a series of practical sessions and is designed to develop the skills required for subsequent advanced modules on the course.
This module provides introduction to the role of Biomedical Scientists within the current UK health care provision landscape. We will explore the role that Health and Care Professions Council (HCPC) and Institute of Biomedical Science (IBMS) play in informing and overseeing education, training and continuing professional development of biomedical scientists in the UK. Moreover, you will be introduced to professional standards and codes of practice specific to biomedical scientists.
This module prepares students for further study and employment by providing an understanding of what science is and how it works. It introduces students to the principles of scientific research and the planning and design of experiments. Students will learn how to effectively analyse literature and communicate science in a variety of methods.
The aim of this is to provide you with an introduction to the biology of microorganisms, to include bacteria, viruses, fungi and protists. Furthermore, you will learn the basis of techniques and practical procedures commonly used in the field of microbiology, with an emphasis on analytical methods relevant in clinical analysis. In addition, the significance of microbes in health and disease will be investigated, also with the support of current research literature.
Effective scientists need to understand how experimentation, qualitative and quantitative analysis drives science forward via the process of attempted falsification and how this is quantified and presented. This module prepares students for further study and employment by providing an understanding of inferential statistical analysis of scientific data. It will enable students to understand, interpret and apply most of the statistical techniques that they will see in published articles and allow them to emulate such analysis in their own work.
Health and disease may be considered two extremes of a continuum. This module will explore the factors that set the graduations between the two extremes. This module is designed to review the nature of and causation of diseases, by considering environmental, genetic, and biologic factors and link the characteristics of disease to the signs and symptoms utilised in diagnosis.
An understanding of the immunological process has been fundamental to many of the advances made in science and medicine. In this module, you will explore the cellular basis of infection via pathogens and the immunological defense system the body deploys in order to prevent the development of infectious disease.
This module introduces you to the principles of nucleic acids manipulation and cloning. The module will include a thorough background on DNA handling, manipulation and analysis. The module will then detail the standard techniques by which DNA can be differently inserted into prokaryotic and eukaryotic cells, and its expression monitored. Classic techniques will be presented together with the more advanced, cutting-edge technologies and approaches.
The dissertation will provide an opportunity for individuals to develop an area of scientific interest arising from either course-based or work-based experience. The focus of the dissertation will be a research-based study, central to which will be some form of hypothesis testing or problem solving. It will enable students to utilise practical, intellectual and decision making skills in novel situations.
This final year module aims to advance and apply your knowledge of what it means to be a Biomedical Scientist, the roles and responsibilities that this profession encompass, as well as to strengthen your understanding of the role that Health and Care Professions Council (HCPC) and Institute of Biomedical Science (IBMS) play in training and continuing professional development of biomedical scientists in the UK. The emphasis will be on reviewing professional standards and codes of practice as well as requirements for the HCPC registrations, including Registration Training Portfolio and Certificate of Competence.
Histology is the science that studies the minute structure, composition and function of tissues. Every tissue is made of specialised cell components playing pivotal functions. When these functions are altered, the cell dysfunctions are reflected into significant histological changes, which are studied in the realm of histopathology. In this module, you will understand the different features and functions of the main classes of tissues, where cells exert specific functions.
Haematology and blood transfusion science are core clinical study areas within Biomedical Science. This module will apply your knowledge of biochemistry, cell biology, genetics and immunology to the study of blood and the major proteins and cells that constitute blood. We will start by studying main types of blood cells and their distinguishing features, to then go on to consider most common diseases of the blood including anaemias, coagulation disorders and blood malignancies.
This module is intended to allow you to draw together a wide range of topics covered at levels 4 and 5 into the applied area of pharmacology and toxicology. This module utilises understanding and application of biochemistry, molecular biology, cell biology, genetics and physiology to solve problems. The interdisciplinary nature of the field provides an ideal opportunity for you to contextualise your studies within an important progressive science.
The module will examine nutrition as it relates to the prevention and treatment of disease and deals with the nutritional aspects of diseases and clinical disorders by integrating students' existing knowledge of physiology, biochemistry and food science. In this module students will also consider the nutritional requirements of humans throughout the lifespan; the changing physiological status and subsequent changes in nutritional requirements will be studied along with a critical appraisal of how this is met with respect to diet, sociological status, geography and education.
This module will provide you with theoretical knowledge and advanced practical experience of core laboratory techniques used to carry out experimental research within the life sciences area. The module is based on a series of practical sessions and will give you experience of performing experimental work, collecting data, and interpreting and presenting results, using a range of media.
This module is designed to provide you with an overview of some fundamental developmental processes that lead to the formation of a multicellular organism from a single zygote, up to the gastrulation process. The module will consider some key developmental models with cellular and molecular events underpinning both development and regeneration, therefore linking core stem cell biology knowledge.
.jpg)
WHY SUFFOLK
2nd in the UK for Career Prospects
WUSCA 20243rd in the UK for spend on academic services
Complete University Guide 20254th in the UK for Teaching Satisfaction
Guardian University Guide 2024
.jpg)

Entry Requirements

Career Opportunities
We anticipate you may wish to progress into laboratory-based careers in clinical or technical roles within NHS setting. However, you will also be well placed to secure jobs as researchers working in universities, pharmaceutical and bioscience companies and institutes.
The transferable skills developed during the course will equip you for a wide range of careers outside the laboratory.
- Scientific publication
- Quality control
- Scientific sales
- Local and central government health authorities.
- Higher level study such as PGCE (e.g. science teacher training), Masters degree or PhD.
Facilities and Resources
Our state-of-art laboratories are located in the James Hehir Building facilitate high quality practical skills teaching. As well as a standard laboratory equipment, there is a range of key specialist equipment to support the practical elements of the modules including cell and tissue culture facilities, imaging facilities (light and fluorescent microscopes), 3D productivity suite, and molecular biology facilities.
You will have access to glassware, pipettes, centrifuges, low temperature and ultra-low temperature storage, analytical balances, there is a range of key specialist equipment to support the practical elements of the modules including chromatography, protein analysis, histology, microscopes, 3D productivity suite, cell biology equipment and molecular biology equipment.
Unibuddy: Chat to our Students and Staff
Related News

- 26 January 2024
.jpg)











.jpg)


.jpg)
.jpg)

-ug_mastheads-1-640x640.jpg)
-april-2024-gregg-brown-photography.jpg)
-april-2024-gregg-brown-photography-2.jpg)
.jpg)


-3.jpg)
